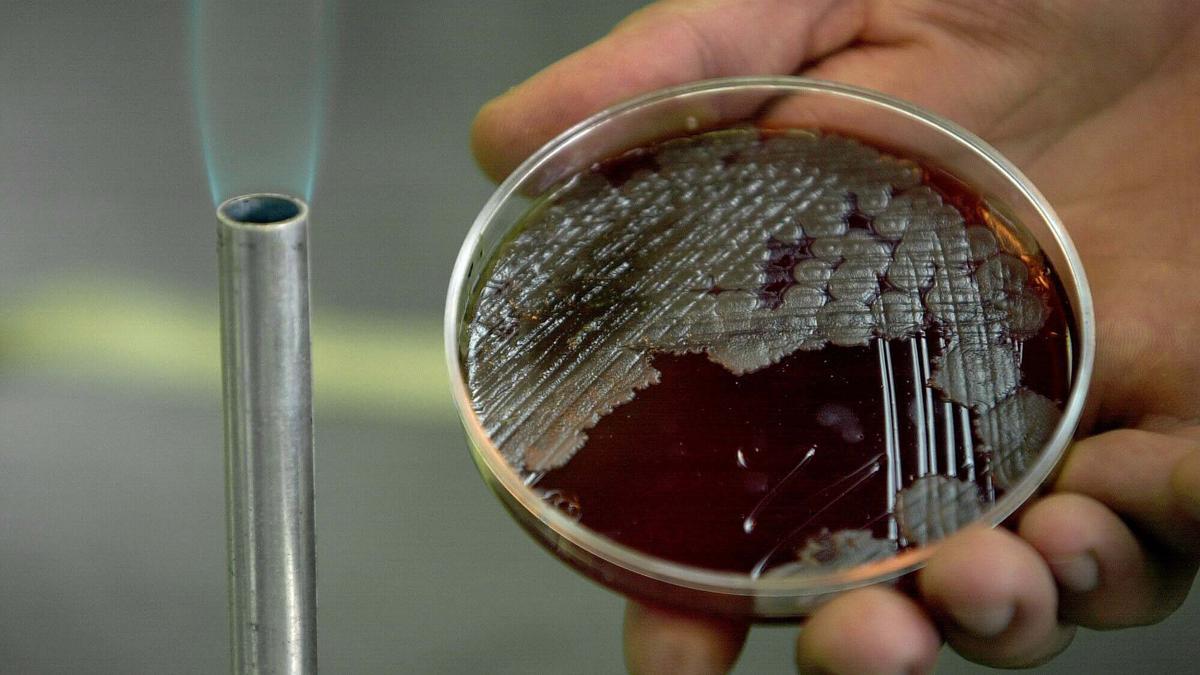

Cada vez es más habitual leer informaciones acerca del aumento de las bacterias resistentes a los antibióticos, en noticias que pueden generar preocupación. Y no es para menos. La resistencia a los antibióticos es “una pandemia silenciosa, el mayor problema sanitario al que se enfrenta la humanidad”, señalaba hace unos meses Bruno González-Zorn, jefe de la Unidad de Resistencia Antimicrobiana de la UCM que ha encabezado una investigación liderada por científicos de la Universidad Complutense de Madrid (UCM) que ha confirmado que el gen npmA2, generador de bacterias resistentes a los antibióticos, ya está ampliamente diseminado en humanos, animales y el medioambiente a nivel global, al haberse identificado su presencia en seis países.
En ese sentido, tal y como señala el presidente del Consejo de Colegios Oficiales de Farmacéuticos del País Vasco, Miguel Ángel Gastelurrutia, la resistencia bacteriana es “un problema importante, sobre todo a nivel hospitalario más que a nivel ambulatorio porque las bacterias resistentes en un hospital pueden ser muy dañinas”. Al fin y al cabo, la resistencia se genera en todos los ámbitos. “Una bacteria no sabe si está en un hospital o en la comunidad, pero es verdad que los antibióticos que se utilizan en la comunidad son más suaves, más cómodos, y son muchos más críticos a nivel hospitalario”, nos cuenta, al tiempo que explica que es un problema porque los precios de los antibióticos “son baratos, hay poco incentivo para investigar nuevos antibióticos y es un tema que preocupa a todos los gobiernos de todo el mundo. No es un tema ni de Euskadi ni de Europa. Es mundial”, resume.
Sin embargo, sí que se están dando pasos para mejorar la situación, o al menos paliarla si no revertirla. Se está trabajando, “están incentivando la investigación en nuevos antibióticos. Hay programas para mejorar el uso de los antibióticos, y yo creo que se está haciendo un esfuerzo muy grande a nivel de todos los agentes sanitarios para mejorar el uso de los antibióticos”, resume Gastelurrutia.
Sin receta
“Hoy en Euskadi te diría que es imposible entre comillas conseguir un antibiótico sin receta. En ese sentido, yo creo que se está mejorando la práctica profesional en todos los ámbitos, y yo creo que vamos bien, aunque es verdad que el tema de las resistencias frente a los antibióticos es un problema a nivel mundial”, añade asimismo. Porque, en lo que a automedicación se refiere, la OMS aconseja lo que ellos denominan la automedicación responsable. “Nosotros la definimos como la automedicación asesorada por un profesional de la salud, como puede ser un farmacéutico”, subraya el presidente del Consejo.
“A nosotros nos piden muchas personas medicamentos sin receta, y primero tenemos que discriminar si es precisa la presencia de receta o no. Cuando se pide algo sin receta, lo que el farmacéutico suele tender a hacer es investigar o evaluar para qué indicación está pidiendo ese medicamento. Muchas veces pedimos un antigripal de la marca equis para una gripe y a lo mejor ese antigripal tiene un antitusivo que no necesitas. Hay que investigar para qué queremos el medicamento y para eso el farmacéutico nos ayuda. Una automedicación responsable es correcta porque descargamos además los centros de salud y la atención primaria, que ya sabemos todos cómo están de presión asistencial”, señala asimismo.